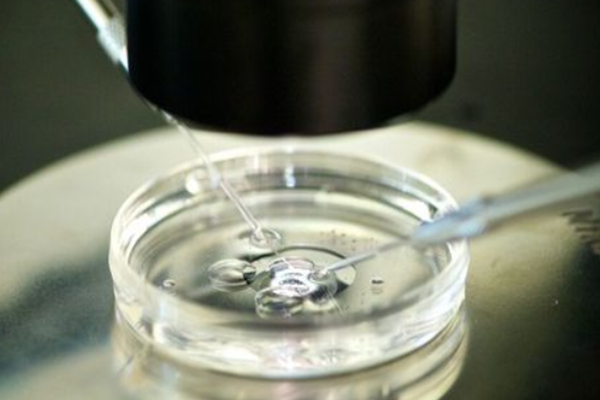
国内试管供卵生孩子,抗糖类125偏高是什么原因

作者:admin
日期:2025-05-22
在体检中,尤其是妇科检查中,糖类抗原125是十分重要的数据,它的升高就说明检查身体出现了一些问题,但并不能直接得出是什么原因引起的糖类抗原125的升高,还需要后续的检查才能明确,所以,如果有检查者的糖类抗原125偏高,那么就要在医生的安排下进行后续的检查,以明确具体的原因,这样才能有效的降低糖类抗原125,那么,抗糖类125偏高是什么原因呢?
妇科疾病
除了癌症会引起糖类抗原125的升高之外,一些普通的妇科疾病也会引起糖类抗原125的升高,比如子宫内膜炎、阴道炎、附件炎等,不同的疾病会有不同的治疗方式,只有针对性治疗,才能让患者尽快恢复健康,有效的降低糖类抗原125,除此之外,在孕妇的早期妊娠的头3个月内,糖类抗原25也有升高的可能,所以,糖类抗原125升高的原因有很多,只有明确了,才能帮助检查者更好的护理身体。
国内正规供卵医院排名,福州三代试管条件正规医院盘点,2026比较新助孕机构推荐选择
国内供卵试管民营医院哪家好,2026试管婴儿男孩费用大概要多少钱?了解试管婴儿的成本?
国内代怀男孩中介,教你做试管如何选择好医*,附2026*殖大夫*率排名
国内代怀生殖中心,2026山东三胎政策最新消息来了,奖励20万可真别信
国内借卵人工代孕公司服务,襄阳市第一人民医院试管婴儿费用清单2026助孕花费预算公布
国内供卵公司名单查询,2026年美国南加州*殖中心(SCRC)实地考察报告
国内供卵怎么收费,2026中山大学附属第一医院试管成功率附费用详情
全国供卵快医院有几家,2026年泰国试管*男孩靠谱吗附详细流程
国内供卵试管民营医院排名,深圳妇幼三代试管费用多少附2026最新试管花费预估
国内供卵需要去几次,2026年男孩子名字文雅有寓意属兔的男孩起名